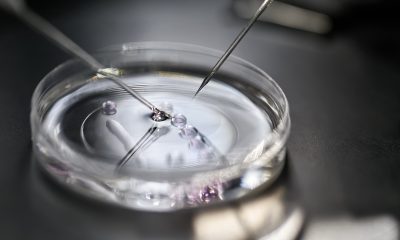

The collaboration will enable the integration of software and payment solutions in participating fertility practices


Guidelines will ensure staff receive additional support and paid leave


More than 90 per cent Americans reported feeling some degree of anxiety about the prospect of starting a family


wawa aims to support fertility patients and close the data gap in women’s health


The programme focuses on improving fertility from a lifestyle perspective


The Femtech and Consumer Innovation Summit is the latest deep dive event part of the Women’s Health Innovation Series


Future Fertility received CE Mark approval for its oocyte assessment software in August and continues to steadily grow its presence across Europe


Villalba brings more than 30 years of industry experience in developing and commercialising innovative products and therapies

The device could reduce the number of cycles required to get pregnant by up to 40 per cent, say developers


The clinic has previously raised €17m in funding to expand to Spain, Germany and Italy